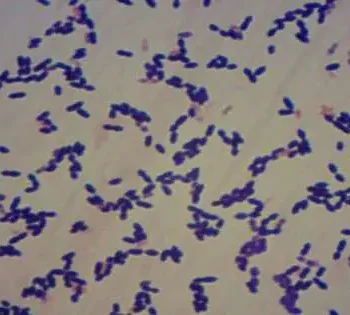

In the event that you own a retro gaming console or have an old roll of pressing tape, you've probably noticed how plastics become yellow
According to a study funded by the National Institutes of Health and the Health Resources and Services Administration, children born to women with high blood lead levels are more likely
A review published in the journal PLOS ONE might one day assist well-being laborers with deciding if microscopic organisms of the species Streptococcus pneumoniae, which cause meningitis—an irritation of the
Trouble is an extreme viewpoint to adjust in computer games. Certain individuals are inclined toward computer games that present a test, though others partake in a simple encounter. To make
Individuals with fair complexion tones are definitely more bound to foster melanoma skin disease than individuals with brown complexion tones. This enormous dissimilarity results from undeniably more than can be